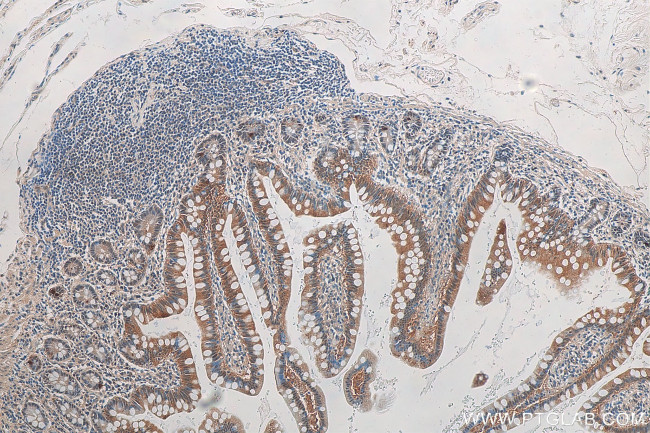
GPBP1 Antibody in Immunohistochemistry (Paraffin) (IHC (P))
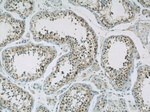
GPBP1 Antibody in Immunohistochemistry (Paraffin) (IHC (P))

Search
Proteintech
GPBP1 Polyclonal Antibody
{{$productOrderCtrl.translations['antibody.pdp.commerceCard.promotion.promotions']}}
{{$productOrderCtrl.translations['antibody.pdp.commerceCard.promotion.viewpromo']}}
{{$productOrderCtrl.translations['antibody.pdp.commerceCard.promotion.promocode']}}: {{promo.promoCode}} {{promo.promoTitle}} {{promo.promoDescription}}. {{$productOrderCtrl.translations['antibody.pdp.commerceCard.promotion.learnmore']}}
产品信息
21622-1-AP
种属反应
宿主/亚型
分类
类型
抗原
偶联物
形式
浓度
规格
纯化类型
保存液
内含物
保存条件
运输条件
产品详细信息
Immunogen sequence: MRTDKKSEF LKALKRDRVE EEHEDESRAG SEKDDDSFNL HNSNSTHQER DINRNFDENE IPQENGNASV ISQQIIRSST FPQTDVLSSS LEAEHRLLKE MGWQEDSEND ETCAPLTEDE MREFQVISEQ LQKNGLRKNG ILKNGLICDF KFGPWKNSTF KPTTENDDTE TSSSDTSDDD DV (293-473 aa encoded by BC000267)
靶标信息
Vasculin is a novel vascular protein differentially expressed in human atherogenesis.
仅用于科研。不用于诊断过程。未经明确授权不得转售。
生物信息学
蛋白别名: DKFZP761C169; GC-rich promoter-binding protein 1; mGPBP; unnamed protein product; Vascular wall-linked protein; Vasculin
基因别名: 1700034P14Rik; AU019836; D230035M11Rik; GPBP; GPBP1; mGPBP; RGD1305492; SSH6; VASCULIN
UniProt ID: (Human) Q86WP2, (Mouse) Q6NXH3
Entrez Gene ID: (Human) 65056, (Mouse) 73274, (Rat) 294734